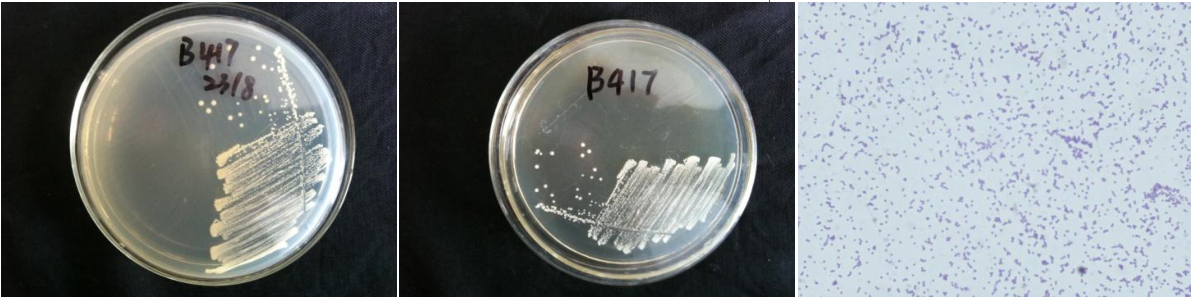

Loading...
| StrainNO | B417 |
| Classification | Staphylococcus |
| 16s rDNA sequence | TATACATGCAAGTCGAGCGAACAGATAAGGAGCTTGCTCCTTTGACGTTAGCGGCGGACGGGTGAGTAACACGTGGGTAACCTAC CTATAAGACTGGAATAACTCCGGGAAACCGGGGCTAATGCCGGATAACATTTAGAACCGCATGGTTCTAAAGTGAAAGATGGTTT TGCTATCACTTATAGATGGACCCGCGCCGTATTAGCTAGTTGGTAAGGTAACGGCTTACCAAGGCAACGATACGTAGCCGACCTG AGAGGGTGATCGGCCACACTGGAACTGAGACACGGTCCAGACTCCTACGGGAGGCAGCAGTAGGGAATCTTCCGCAATGGGCGAA AGCCTGACGGAGCAACGCCGCGTGAGTGATGAAGGTCTTCGGATCGTAAAACTCTGTTATTAGGGAAGAACAAATGTGTAAGTAA CTATGCACGTCTTGACGGTACCTAATCAGAAAGCCACGGCTAACTACGTGCCAGCAGCCGCGGTAATACGTAGGTGGCAAGCGTT ATCCGGAATTATTGGGCGTAAAGCGCGCGTAGGCGGTTTCTTAAGTCTGATGTGAAAGCCCACGGCTCAACCGTGGAGGGTCATT GGAAACTGGGAAACTTGAGTGCAGAAGAGGAAAGTGGAATTCCATGTGTAGCGGTGAAATGCGCAGAGATATGGAGGAACACCAG TGGCGAAGGCGACTTTCTGGTCTGTAACTGACGCTGATGTGCGAAAGCGTGGGGATCAAACAGGATTAGATACCCTGGTAGTCCA CGCCGTAAACGATGAGTGCTAAGTGTTAGGGGGTTTCCGCCCCTTAGTGCTGCAGCTAACGCATTAAGCACTCCGCCTGGGGAGT ACGACCGCAAGGTTGAAACTCAAAGGAATTGACGGGGACCCGCACAAGCGGTGGAGCATGTGGTTTAATTCGAAGCAACGCGAAG AACCTTACCAAATCTTGACATCCTTTGACAACTCTAGAGATAGAGCCTTCCCCTTCGGGGGACAAAGTGACAGGTGGTGCATGGT TGTCGTCAGCTCGTGTCGTGAGATGTTGGGTTAAGTCCCGCAACGAGCGCAACCCTTAAACTTAGTTGCCAGCATTTAGTTGGGC ACTCTAAGTTGACTGCCGGTGACAAACCGGAGGAAGGTGGGGATGACGTCAAATCATCATGCCCCTTATGATTTGGGCTACACAC GTGCTACAATGGACAATACAAAGGGCAGCTAAACCGCGAGGTCATGCAAATCCCATAAAGTTGTTCTCAGTTCGGATTGTAGTCTGCAACTCGACTACATGAAGCTGGAATCGCTAGTAATCGTAGATCAGCATGCTACGGTGAATACGTTCCCGGGTCTTGTACACACC GCCCGTCACACCACGAGAGTTTGTAACACCCGAAGCCGGTGGAGTAACCATTTATGGAGCTAGCCGT |
| Strain Morphology Photos | |
| Morphological Description | round;milky white;steamed bun shaped;edge neatly;bright;sticky;spherical;no spore |